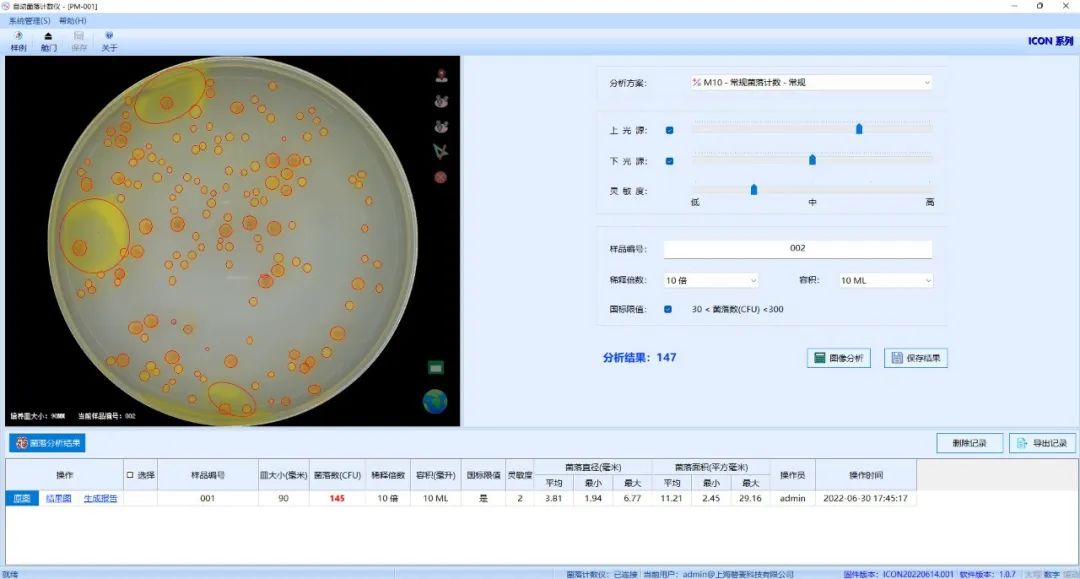
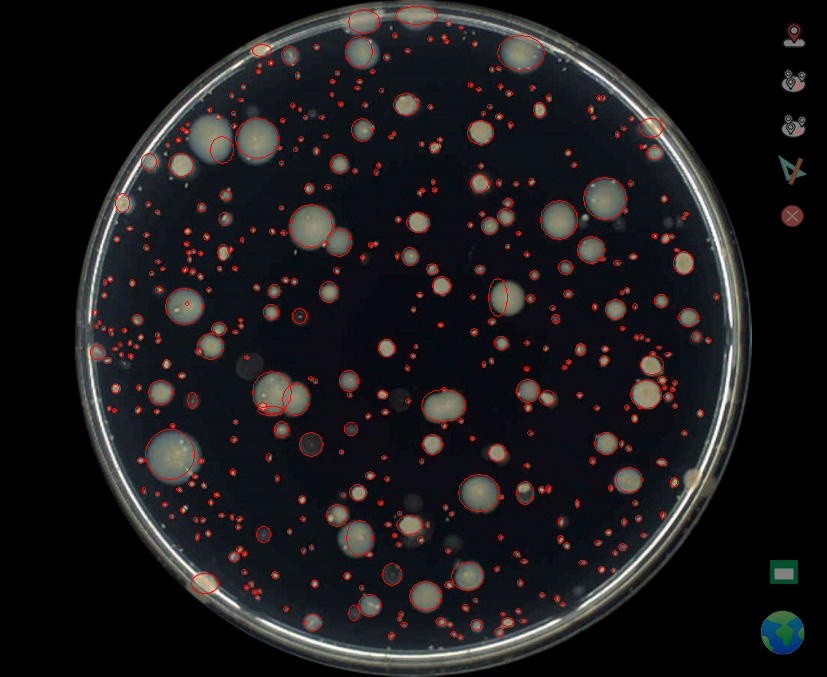

新聞應用
更新時間:2024-09-25 瀏覽次數:638
菌落總數測定是用來判定食品被細菌污染程度以及衛(wèi)生質量的標準,它反映食品在生產過程中是否符合衛(wèi)生要求,以便對被檢樣品做出適當的衛(wèi)生學評價,菌落總數的多少在一定程度上標志著食品衛(wèi)生質量的優(yōu)劣。
當前,有相當一部分實驗室仍然采用傳統的人工肉眼計數方法,借助放大鏡的觀察,用記號筆點擊每一個菌落,然后數點的總數,后得出菌落總數的數值,這樣不僅會造成人眼視覺疲勞,而且對于數量比較多的平板計數無疑是一項繁重的任務。

平板菌落計數法是一種常見的活菌計數法。通過梯度稀釋待測的菌液,在固體培養(yǎng)基凝固前均勻混合一定體積的稀釋菌液,或者在已凝固的固體培養(yǎng)基平板上涂布菌液,恒溫培養(yǎng)后,就能數出平板上出現的菌落數,結合菌液的稀釋度,就能計算出樣本的菌落總數。
在微生物檢測中,計算菌落總數是常見的實驗分析項目,在檢驗的過程中,任何一個環(huán)節(jié)都需要謹慎仔細,才能保證檢測結果的準確性。實驗室較為常用的檢測方法就是國標法采用的平板計數法,然而其操作時間偏長,過程復雜,往往需要花費大量的時間,效率也無法保證。盡管有更加簡單,節(jié)約時間的方法,但這些方法成本又相對較高,并且實驗的種類也比較單一,因此,新的菌落計數技術在檢測方法中的應用需要得到我們更加積極地關注,從而使得檢測更加經濟、便捷和可靠。
ICON自動菌落計數儀能夠快速對菌落培養(yǎng)皿進行拍攝、識別和計算,檢測速度高達4秒/皿,為檢測人員節(jié)省更多時間。而且改變了“肉眼+大腦”的傳統檢測模式,超高的檢測效率可以降低50%的人工成本。

01極簡操作界面
02智能AI記憶識別

03準確率超過95%
ICON全自動菌落計數儀,由圖像采集系統和菌落統計分析軟件構成,具有菌落統計、典型菌篩選、菌株特征檢測與描述等功能,適用于生物醫(yī)藥、檢驗檢疫、疾病控制、質量監(jiān)督、環(huán)境監(jiān)測、食品衛(wèi)生,以及大專院校、研究院所等領域中的微生物菌落分析和科學研究。
關注磐麥科技公眾號,申請免費試用